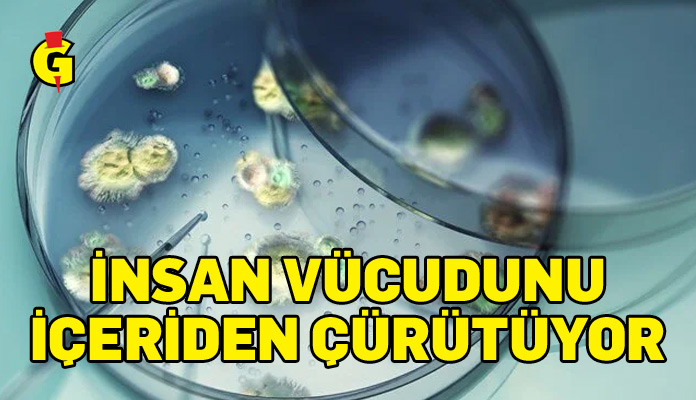

ABD’de hızla yayılan ölümcül bir mantar türü, insan vücudunu içeriden çürüterek akciğerlerden beyin ve kalbe kadar ilerleyebiliyor.
ABD’de insan dokusunu içeriden çürütebilen ölümcül bir mantar türü hızla yayılıyor. Uzmanlar, iklim değişikliğiyle birlikte bu tehdidin daha da büyüyebileceği uyarısında bulunuyor.
HAVADA TAŞINIYOR, FARK EDİLMEDEN SOLUNUYOR
“Aspergillus fumigatus” adlı mantar, havada taşınabilen mikroskobik sporları sayesinde neredeyse kaçınılması imkansız bir tehlike oluşturuyor.
Bu sporlar fark edilmeden solunuyor ve özellikle bağışıklık sistemi zayıf bireylerde ciddi akciğer enfeksiyonlarına yol açabiliyor.
Mantarın yol açtığı aspergillozis hastalığı, organ yetmezliği ve ölümle sonuçlanabiliyor. Kanser, astım veya HIV gibi bağışıklığı baskılayan hastalıkları olan bireyler en büyük risk grubunu oluşturuyor.
SICAK VE NEMLİ BÖLGELERDE YAYILIYOR
ABD’nin Florida, Louisiana, Teksas, Georgia ve Kaliforniya gibi sıcak ve nemli iklimlere sahip eyaletlerinde mantarın yoğunlaştığı tespit edildi. Tarımsal faaliyetlerin de yayılmayı hızlandırdığı belirtiliyor.
New York, Houston ve Los Angeles gibi büyük şehirlerde ise nüfus yoğunluğu ve yaşlanan altyapı mantarın yayılması için elverişli bir zemin oluşturuyor.
TAKİBİ ZOR, VERİLER EKSİK
ABD’de aspergillozis bildirimi zorunlu olmayan bir hastalık olduğu için enfeksiyon, hastaneye yatış ve ölüm sayıları düzenli olarak izlenmiyor. Bu da tehdidin büyüklüğünü tespit etmeyi güçleştiriyor.
Uzmanlar, bağışıklığı zayıf bireylerin toprakla temas etmekten, bahçecilik faaliyetlerinden ve küflü ortamlardan kaçınmalarını, tozlu bölgelerde maske takmalarını ve yaşadıkları ortamda hava temizliğine dikkat etmelerini öneriyor.
“YÜZ BİNLERCE HAYAT TEHLİKEDE”
University of Manchester’dan Dr. Norman van Rhijn, Financial Times’a yaptığı açıklamada, “Bu, yüz binlerce hayatı ilgilendiriyor. Önümüzdeki 50 yılda nerede ne yetiştiği ve ne tür enfeksiyonlara yakalandığımız tamamen değişecek” dedi.
Aspergillozis vakalarının yaklaşık 400 bini, kronik akciğer enfeksiyonuna dönüşüyor. Daha az görülen ama çok daha ölümcül olan invaziv aspergillozis ise mantarın akciğerlerden beyin, kalp ve böbreklere yayılmasıyla sonuçlanabiliyor.
EN ÖLÜMCÜL ENFEKSİYONLARDAN BİRİ
Organ nakli geçiren hastalarda enfeksiyondan sonra bir yıllık hayatta kalma oranı yalnızca yüzde 59. Kök hücre nakli geçirenlerde ise bu oran yüzde 25’e düşüyor.
Yoğun bakım otopsileri, aspergillozisin en ölümcül dört enfeksiyon arasında yer aldığını gösteriyor.
“BİLİM KURGU DEĞİL, GERÇEK”
Uzmanlar, farklı mantar türlerinin birleşerek direnci hızla yaydığını ve sorunun ABD topraklarına çoktan yerleştiğini belirtiyor.
DSÖ, daha güvenli ilaçlara yatırım yapılması, testlerin hızlandırılması ve sağlık çalışanlarının eğitilmesi çağrısında bulundu.
Columbia Üniversitesi’nden enfeksiyon hastalıkları uzmanı Dr. Vyas, “Bu bir bilim kurgu değil. Bu enfeksiyonlar gerçek ve biz buna hazır değiliz” dedi.






































